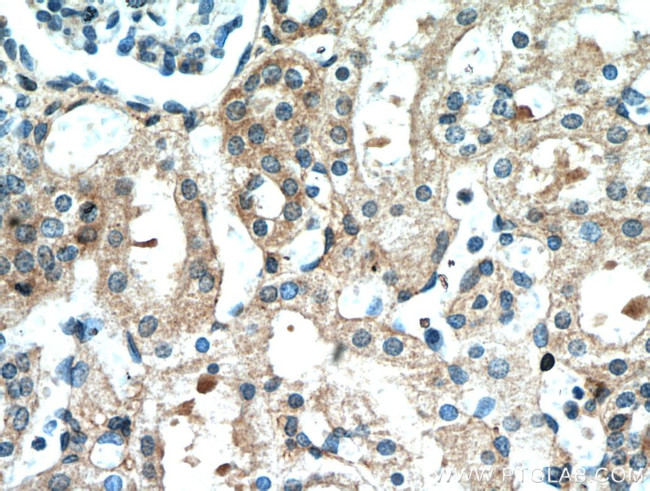
Frizzled 10 Antibody in Immunohistochemistry (Paraffin) (IHC (P))

Search
Proteintech
Frizzled 10 Polyclonal Antibody
{{$productOrderCtrl.translations['antibody.pdp.commerceCard.promotion.promotions']}}
{{$productOrderCtrl.translations['antibody.pdp.commerceCard.promotion.viewpromo']}}
{{$productOrderCtrl.translations['antibody.pdp.commerceCard.promotion.promocode']}}: {{promo.promoCode}} {{promo.promoTitle}} {{promo.promoDescription}}. {{$productOrderCtrl.translations['antibody.pdp.commerceCard.promotion.learnmore']}}
产品信息
18175-1-AP
种属反应
已发表种属
宿主/亚型
分类
类型
抗原
偶联物
形式
浓度
规格
纯化类型
保存液
内含物
保存条件
运输条件
产品详细信息
Immunogen sequence: SMDMERPGD GKCQPIEIPM CKDIGYNMTR MPNLMGHENQ REAAIQLHEF APLVEYGCHG HLRFFLCSLY APMCTEQVST PIPACRVMCE QARLKCSPIM EQFNFKWPDS LDCRKLPNKN DPNYLCMEAP NNGSDEPTRG SGLFPPLFRP QRPHSAQEHP LKDGGPGRGG CDNPGKFHHV EKSASCAPLC TPGVDVYWSR EDKRFAVV (23-229 aa encoded by BC074998 )
靶标信息
FZD10/Frizzled-10 is a 581 amino acid protein belonging to the G-protein coupled receptor Fz/Smo family and containing a signal peptide, a cysteine-rich domain in the N-terminal, seven transmembrane domains and a C-terminal PDZ domain-binding motif. It is involved in transduction, intercellular transmission of polarity information during tissue morphogenesis in differentiated tissues and as a receptor for Wnt proteins. FZD10 is expressed highly in placenta, fetal kidney, fetal lung, brain cerebellum, cerebral cortex, medulla and spinal cord with very low levels in total brain, frontal lobe, temporal lobe, putamen, adult brain, heart, lung and skeletal muscle.
仅用于科研。不用于诊断过程。未经明确授权不得转售。
生物信息学
蛋白别名: CD350; CD350 antigen; frizzled 10, seven transmembrane spanning receptor; frizzled family receptor 10; frizzled homolog 10; frizzled homolog 10, pseudogene 1; Frizzled-10; Fz-10; FzE7
基因别名: CD350; FZ-10; Fz10; FZD10; Fzd10-ps1; FzE7; hFz10
UniProt ID: (Human) Q9ULW2, (Mouse) Q8BKG4
Entrez Gene ID: (Human) 11211, (Rat) 363913, (Mouse) 93897